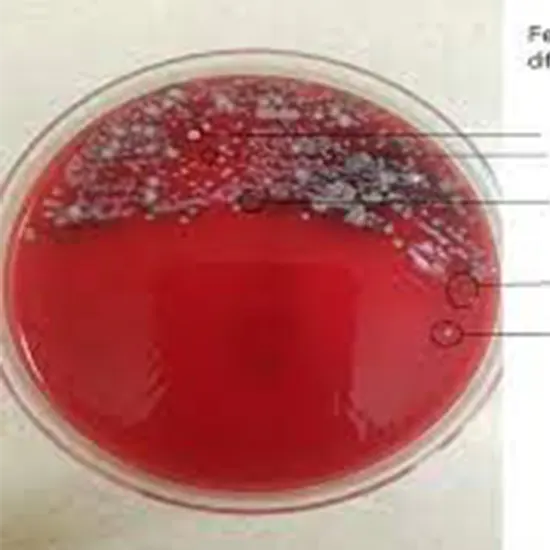

Book Aspirate Culture & Sensitivity Appointment Online Near me at the best price in Delhi/NCR from Ganesh Diagnostic. NABL & NABH Accredited Diagnostic centre and Pathology lab in Delhi offering a wide range of Radiology & Pathology tests. Get Free Ambulance & Free Home Sample collection. 24X7 Hour Open. Call Now at 011-47-444-444 to Book your Aspirate Culture & Sensitivity at 50% Discount.
A lab test to look for infection in the small intestine is called a small intestinal aspirate and culture.
To determine whether you have a joint infection and to pinpoint the microorganisms responsible for your current condition, the Culture and Sensitivity - Synovial Fluid test is frequently administered. Have your synovial fluid or joint fluid tested as soon as possible if you've been exhibiting any of the symptoms described below:
If you exhibit symptoms of an excessive amount of bacteria developing in your intestinal tract, your doctor can request this test for you. Very often, different tests are performed initially. Seldom is this test conducted outside of a laboratory environment. Most often, a breath test that looks for too many germs in the small intestine has taken its place.
Little numbers of bacteria are typically found in the small intestine and don't harm people. Nonetheless, the test might be carried out if your doctor believes that an overgrowth of intestinal bacteria brings on diarrhoea.
You don't need to perform any specific preparation for the test. Still, depending on your doctor's recommendations, you might need to stop taking additional medicine 6 to 8 hours before the test because it could affect the results. Your doctor can accurately diagnose your joint discomfort and recommend a successful course of treatment once they have evaluated and examined the joint fluid in your body.
Your doctor would ask you to remove your clothes and put on the hospital gown before instructing you to relax and lay back down while he cleaned the surgical site with an antiseptic.
| Test Type | Aspirate Culture & Sensitivity |
| Includes | Aspirate Culture & Sensitivity (Pathology Test) |
| Preparation | |
| Reporting | Within 24 hours* |
| Test Price |
₹ 600
|

Early check ups are always better than delayed ones. Safety, precaution & care is depicted from the several health checkups. Here, we present simple & comprehensive health packages for any kind of testing to ensure the early prescribed treatment to safeguard your health.